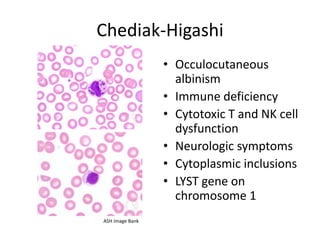
Chediak-Higashi
• Occulocutaneous
albinism
• Immune deficiency
• Cytotoxic T and NK cell
dysfunction
• Neurologic symptoms
• Cytoplasmic inclusions
• LYST gene on
chromosome 1
ASH Image Bank

This document provides an overview of platelet function and dysfunction. It discusses platelet production, structure, activation pathways, assessment of function, and inherited and acquired disorders. Key points include: platelets are produced from megakaryocytes at a rate of 1 trillion per day; contain granules storing factors like ADP and serotonin; activate via receptors for collagen, thrombin, ADP; aggregation is mediated by integrin GP IIb/IIIa; testing includes aggregometry and PFA-100; inherited disorders impact receptors like Glanzmann thrombasthenia or Bernard-Soulier syndrome; and acquired causes include medications like aspirin or clopidogrel that inhibit platelet activation pathways.